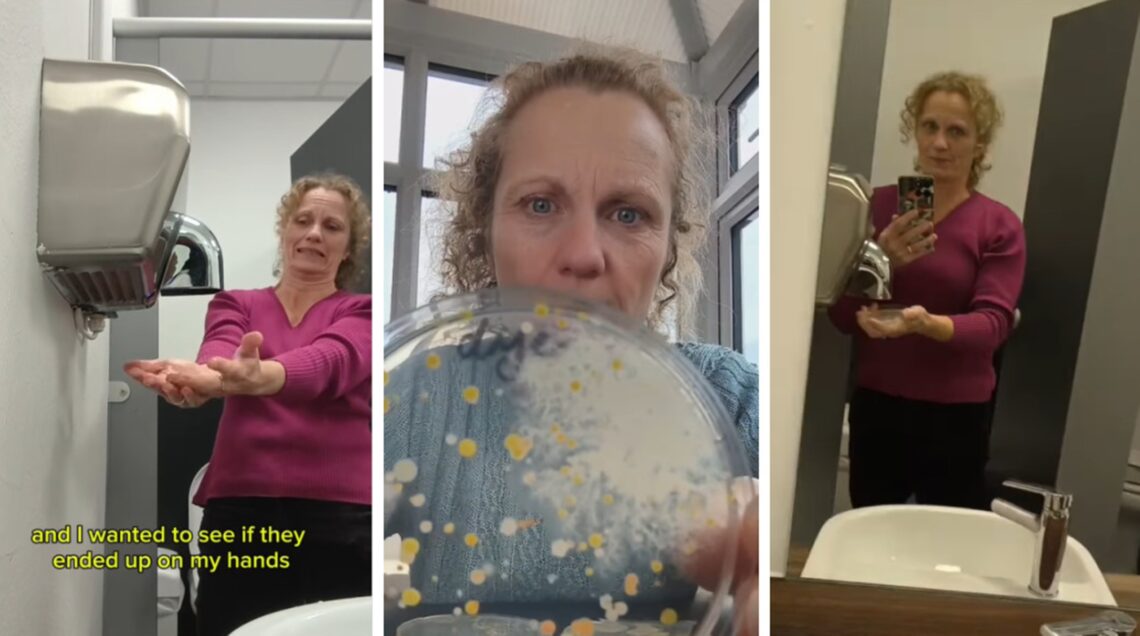
Naukowczyni Ruth MacLaren sprawdza, jakie bakterie bytują w suszarkach do rąk

Wszyscy mówią, żeby nie używać suszarek do rąk. Naukowczyni pokazała, dlaczego
Naukowczyni Ruth MacLaren powraca z kontynuacją eksperymentu, który rok temu zdobył aż 28 milionów wyświetleń. Nagranie pokazywało, co wydostaje się z wnętrza suszarek do rąk w toaletach publicznych. „Minął rok i wróciłam, żeby sprawdzić, czy coś się zmieniło” – zapowiada swoją nową rolkę, na której demonstruje, jakie bakterie są na jej rękach przed umyciem, a jakie po umyciu i użyciu suszarki. Ten widok szokuje!
Co wydostaje się z wnętrza suszarek do rąk?
Ruth MacLaren to naukowczyni i nauczycielka mieszkająca z rodziną w North Devon w Anglii. W 2014 roku Ruth założyła Devon Science – organizację, która prezentuje ciekawe i interaktywne pokazy naukowe, warsztaty i imprezy dla szkół, rodzin i dzieci. Ruth aktywnie angażuje się także w szerzenie wiedzy naukowej w social mediach. Na swoim profilu @devon_science na Instagramie regularnie publikuje relacje z warsztatów i eksperymentów, które przeprowadza na co dzień. Jedno z takich nagrań miało aż 28 milionów wyświetleń na TikToku!
Bohaterką viralowego eksperymentu była suszarka do rąk. Naukowczyni w ramach szybkiego testu postanowiła sprawdzić, co tak naprawdę wylatuje z urządzeń, które służą do wysuszenia rąk. W tym celu pod wlot z ciepłym powietrzem Ruth podłożyła płytkę agarową, a następnie zademonstrowała efekty hodowli kultur mikroorganizmów. Na nagraniu widać, że płytka została pokryta licznymi koloniami bakterii w różnych kolorach. Ruth postanowiła zidentyfikować, jakie konkretnie bakterie wydostały się z wnętrza suszarki.
„Mamy głównie gatunki Micrococcus, Staphylococcus i Bacillus. Raczej nie będą szkodliwe, ale ja osobiście nie chcę, żeby taka ilość bakterii dmuchała na moje świeżo wyczyszczone ręce!” – skwitowała wówczas autorka nagrania.
Nagranie Ruth wywołało gorącą dyskusję o higienie w toaletach publicznych i realnym wpływie takich urządzeń na zdrowie. W komentarzach pojawiały się zarówno głosy przerażenia, jak i uspokajające opinie ekspertów. Część osób deklarowała, że po obejrzeniu testu już nigdy nie skorzysta z suszarki, inni żartobliwie podkreślali, że „wiedzieli to od zawsze”.
„Bakterie wychodzą z suszarek do rąk”
Naukowczyni postanowiła wrócić do tematu po roku i przeprowadziła nowy test, tym razem dodając pewien element.
„Ponownie przetestowałam suszarkę do rąk, którą tak wielu widziało w zeszłym roku, ale tym razem przetestowałam też ręce przed i po jej użyciu” – wyjaśniła w opisie nowej rolki.
W ramach testu naukowczyni zebrała cztery próbki: z wlotu suszarki, z powietrza w pomieszczeniu, odcisk palców przed umyciem rąk, a także odcisk palców po umyciu i wysuszeniu ich suszarką. Wszystkie płytki Ruth opisała, a następnie inkubowała na kilka dni. Efekty były widoczne gołym okiem.
Rozwiń
Po inkubacji płytka podstawiona pod urządzenie suszarki pokryła się licznymi koloniami bakterii. Naukowczyni wskazuje na dużą różnorodność mikroorganizmów. Płytka z powietrza w pomieszczeniu również zapełniła się koloniami bakterii, ale było ich znacznie mniej niż w przypadku suszarki, co sugeruje, że faktycznie wewnątrz suszarek oraz w zakurzonych otworach wentylacyjnych mogą rozwijać się mikroorganizmy.
Największe poruszenie wywołał jednak widok płytki z odciskiem palców po użyciu suszarki. Wygląda na to, że bakterii jest na niej więcej niż przed umyciem rąk, co już samo w sobie jest materiałem na viral.
„Ten test, wydaje się, pokazuje, że moje ręce mają więcej bakterii po użyciu suszarki do rąk, ale nie jestem przekonana, że to prawda” – podkreśla Ruth. „Wiem jednak, że bakterie wychodzą z suszarek do rąk. Mieszkają wewnątrz maszyny, na zakurzonych wlotach” – dodaje.
Choć płytka agarowa przedstawiająca stan po użyciu suszarki wyglądała imponująco, bakterie zasiedlające ją – jak wyjaśniła naukowczyni – okazały się głównie powszechnymi mikroorganizmami środowiskowymi, które naturalnie występują w powietrzu i na skórze. Ruth zaznaczyła, że jej nagranie nie jest eksperymentem naukowym, a szybkim testem, który miał za zadanie jedynie zobrazować, co kryje się za tak niepozorną czynnością jak suszenie rąk. „Może to być świetny projekt dla osoby studiującej mikrobiologię” – podsumowała.
Dyskusja, którą wywołał film, pokazała jednak coś ważniejszego: jak bardzo ciekawi nas to, co niewidzialne. Zdaje się, że taki namacalny dowód w postaci wyhodowanych na płytce bakterii działa na naszą wyobraźnię zdecydowanie bardziej niż powtarzane jak mantra zdanie: nie korzystaj z suszarek do rąk, bo to zbiorowisko bakterii.
Używasz suszarek do rąk w toaletach publicznych?
Zobacz także

„Objawy tężyczki łatwo pomylić z udarem, padaczką czy zawałem serca” – mówi neurolog Dominik Kobylarek

Katarzyna Dinst: „Toalety dostosowane do osób z niepełnosprawnością często są zamykane na klucz. Absurd. Gdzie tu jest równy dostęp?”

Jesteś „toaletową czytaczką”? Czytasz, kichasz, wycierasz nos, siedząc na toalecie? W ten sposób niszczysz sobie zdrowie. Rozmawiamy z Panią Fizjotrener
Polecamy

Oddali ciała dla nauki. Uniwersytet Rzeszowski pożegnał i oddał hołd pięciu osobom

Jane Goodall: „Człowiek, który kieruje się w życiu bystrym umysłem, ale zapomina o sercu, to zwykły cwaniak”

Nauczyciel: „Większość dzieci nie potrafi już wykonywać podstawowych czynności”

Przypomina rękawiczkę, można ją „zdjąć” i bezprzewodowo wykonywać różne czynności. To pierwsza tak szybka bioniczna ręka na świecie
się ten artykuł?









